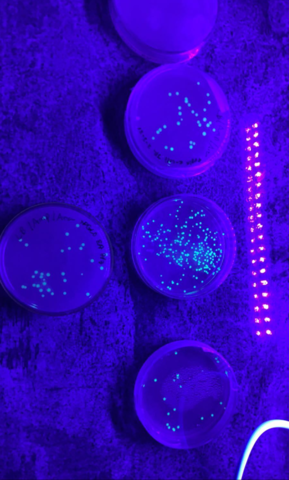
PGLO Lab

-
First time being introduced to STEM. This was an amazing experience that all fifth-grade students at my school got to do. But it really opened my eyes to the mix between science and math.
-
After fifth grade, I moved to a new school. During class one day my teacher asked about ten students in our grade if we wanted to be a part of an after-school program, STARBASE 2.0. Of course, I said yes! We got to build robots and program them.
-
 Sophomore year of high school we had the opportunity to tour our county's technical school. The biotechnology program is what really caught my eye, extremely intimidating but it looked like it would be amazing!
Sophomore year of high school we had the opportunity to tour our county's technical school. The biotechnology program is what really caught my eye, extremely intimidating but it looked like it would be amazing! -
 By the end of my first day, I was terrified. I felt like I wasn't going to be smart enough to be in the class. Ms. Phillips, my instructor, made it seem like it was going to be the hardest class I was going to take, she was right. As soon as I got out of class I texted my mom and told her that I needed to drop out.
By the end of my first day, I was terrified. I felt like I wasn't going to be smart enough to be in the class. Ms. Phillips, my instructor, made it seem like it was going to be the hardest class I was going to take, she was right. As soon as I got out of class I texted my mom and told her that I needed to drop out. -
My first lab was nerve-racking. Everyone was nervous about making sure we did good on the lab. The room was in complete silence until everyone had finished. We had to make sure that we mixed the exact amount of dyes per Ms. Phillips instructions. On top of that we also had to pipette the solution into the exact middle of the circle. I think that we all thought this was going to be such a hard lab but this was the easiest one of the next two years.
-
 As junior year went on, I became more and more comfortable with being in a lab. I had finally convinced myself that I was smart enough to be in the class. Along with gaining confidence I gained a family that I never thought I'd have. Even with some of them being annoying, I love all of them.
As junior year went on, I became more and more comfortable with being in a lab. I had finally convinced myself that I was smart enough to be in the class. Along with gaining confidence I gained a family that I never thought I'd have. Even with some of them being annoying, I love all of them. -
First bacteria lab after all the quarantine. I was definitely behind all the other people in my class, but I knew that I wasn't going to give up on this class. Also, this is by far the coolest lab of the year that we've done.
First bacteria lab after all the quarantine. I was definitely behind all the other people in my class, but I knew that I wasn't going to give up on this class. Also, this is by far the coolest lab of the year that we've done. -
 It was crazy to think how our first year of the program could end so quick. The past year had been the best class I had ever taken. I had been pushed to my limits of learning taking this class, but it will always be the most rewarding thing I have ever done.
It was crazy to think how our first year of the program could end so quick. The past year had been the best class I had ever taken. I had been pushed to my limits of learning taking this class, but it will always be the most rewarding thing I have ever done. -
 My last first day of school. This was a bittersweet moment. I was very excited to meet my new teacher and start a new year with the class I had gotten so close with. I knew I was in store for another great year learning biotechnology.
My last first day of school. This was a bittersweet moment. I was very excited to meet my new teacher and start a new year with the class I had gotten so close with. I knew I was in store for another great year learning biotechnology. -
 I absolutely loved our new teacher. We were learning and having fun every day. I kept gaining more knowledge about science and about myself. I was able to get a feel about how college classes were going to be.
I absolutely loved our new teacher. We were learning and having fun every day. I kept gaining more knowledge about science and about myself. I was able to get a feel about how college classes were going to be. -
 Every second-year student had to do a research project. I had no idea where to even start on mine, but with the help of my teacher I was able to come up with a project to do. I was going to be testing the antimicrobial properties in plants. Which is just basically determining if they could kill bacteria.
Every second-year student had to do a research project. I had no idea where to even start on mine, but with the help of my teacher I was able to come up with a project to do. I was going to be testing the antimicrobial properties in plants. Which is just basically determining if they could kill bacteria. -
 I had worked on this project for months and knew everything that about it. Going in front of about 30 people, including my parents and peers, I was terrified. I felt like I wasn't smart to present this in front of everyone. When I finally began by presentation, the nerves went away. I was comfortable talking about my ups and downs during my project.
I had worked on this project for months and knew everything that about it. Going in front of about 30 people, including my parents and peers, I was terrified. I felt like I wasn't smart to present this in front of everyone. When I finally began by presentation, the nerves went away. I was comfortable talking about my ups and downs during my project. -
 All of my hard work throughout the past two years had paid off. Not only did I get two different certifications, but I also received a $1,000 scholarship. This scholarship was for a second-year student who was not only book smart but also knowledgeable in the lab too.
All of my hard work throughout the past two years had paid off. Not only did I get two different certifications, but I also received a $1,000 scholarship. This scholarship was for a second-year student who was not only book smart but also knowledgeable in the lab too.
Plan projects on a visual timeline
Map milestones, phases, deadlines, and key events in one place so the sequence is easier to see and share. Timetoast is a timeline maker for work, school, research, and stories.